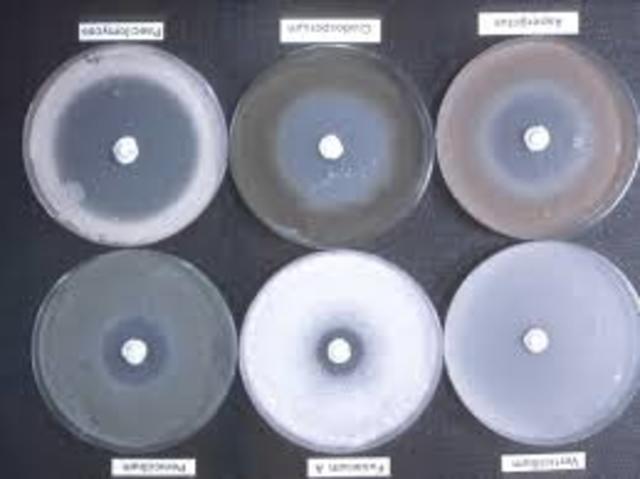
antibiosis

-
considerado el descubridor del mundo microbiano
Fue el primero en descubrir microorganismos en aguas estancadas y realizo observaciones en bacterias descubiertas en el sarro dental
creador del microscopio Leeuwenhoek ,eran diferentes a los actuales. La lente era única, diminuta y casi esférica. La muestra, era colocada en un alfiler romo, unido a la placa posterior y se enfocabamanipulando dos tornillos que variaban de posición el alfiler con respecto a la lente. -
Bassi, asocia por primera vez la presencia de un hongo a una enfermedad (malasegno) presente en gusanos de seda
-
Eichstedt, identifica por primera vez a un microorganismo (un hongo) como el agente etiológico de una enfermedad cutánea humana (pitiriasis versicolor).
-
Semmelweis demostró que las infecciones puerperales eran originadas a partir de microorganismos que eran transmitidos por las manos de médicos y estudiantes de medicina, durante el examen físico de las puerperas. Por lo que para contrarrestar dicha situación propuso el lavado de manos, lo que inicialmente se realizaba con cloruro de cal
-
Semmelweis, establece la etiología de las fiebres puerperales
La infección puerperal es una mutación séptica, localizada o generalizada, que se produce en los primeros 15 días del puerperio como consecuencia de las modificaciones y penetraciones que el embarazo y parto causan sobre el aparato genital -
Devaine, observa por primera vez la presencia en la sangre de animales enfermos de un microorganismo patógeno, Bacillus anthracis
-
Pasteur demostró que los microbios vivos pasan a través del aire con partículas de polvo, y que el algodón sirve de filtro para impedir el paso de las partículas.
-
Los microbios debían ser los causantes de las infecciones de las heridas” Estaba convencido de que las heridas se podían liberar de las bacterias si se las protegían con la aplicación de una sustancia que matara a los microbios. Así sentó las bases de su método antiséptico.
-
Lister, introduce la asepsia quirúrgica, pulverización fenol en las salas donde se intervenía quirúrgicamente
-
Obermeier, encuentra por primera vez una bacteria, Borrelia, en la sangre de un enfermo de fiebres recurrentes.
Es un microorganismo microaerófilo. Causa enfermedades zoonóticas en humanos transmitidas principalmente por las garrapatas y piojos, dependiendo de la especie. Existen 37 especies conocidas de las Borrelia -
Koch, descubre la bacteria responsable de la tuberculosis y establece los postulados para demostrar que un microorganismo es la causa de una determinada enfermedad
-
Koch ideo un método para reproducir bacterias en un medio de cultivo sólido hecho con gelatina, e introdujo el método de la placa para asegurar cultivos puros.
El uso de un medio sólido fue una idea nueva, ya que hasta esa época se habían empleado casi exclusivamente infusiones vegetales y otros líquidos, lo que facilito la obtención de cultivos puros de bacterias para su estudio individual. -
Pasteur, descubre la vacuna de la rabia. Inocula saliva de un perro rabioso a un conejo, deseca la médula y la inocula al hombre (al principio fuertes problemas secundarios).
-
Winogradsky descubrió las bacterias quimiosintéticas, puso de manifiesto la participación de los microorganismos en el ciclo de la urea y fue uno de los primeros en estudiar las bacterias simbióticas
-
Winogradsky estableció que las bacterias funcionan según dos modelos: la aerobiosis, que se basa en el consumo de oxígeno; y la anaerobiosis, que permite a las bacterias vivir en un ambiente desprovisto por completo de oxígeno.
-
Los hermanos Wright diseñan un biplano propulsado a motor y logran por primera vez en la historia un vuelo tripulado de corta duración, dando pie al inicio de la aviación
-
en el año 1905 varios microbiólogos habían demostraron que las enfermedades víricas conocidas se debían a agentes patógenos minúsculos y no a las toxinas, los virus siguieron siendo invisibles; y su naturaleza, desconocida
-
fue el descubridor de la “enfermedad de Chagas” o tripanosomiasis americana, en 1909, durante la construcción del ferrocarril en el norte de brasil. El trabajo de Chagas es único ya que fue el único investigador hasta ahora en describir completamente una nueva enfermedad infecciosa: su patógeno, su vector (Triatominae, mejor conocida como “vinchuca” o “barbeiros”), su huésped, sus manifestaciones clínicas y su epidemiología.
-
La noche del 12 de Abril, el majestuoso trasatlántico Titanic, se hunde al colisionar contra un Iceberg, tras haber sido presentado al mundo como un barco definitivo e indestructible. Las consecuencias que tuvo la cadena de fallos en su rescate, fueron históricas, por ejemplo el uso de S.O.S como mensaje universal de socorro o la asignación de frecuencias exclusivas de emergencia en el uso de la radio
-
En Septiembre de 1928, durante sus investigaciones sobre la Gripe, y de manera accidental, Fleming notó que una colonia de un hongo, que había crecido como contaminante en un cultivo de Staphilococcus aureus, afectaba a las colonias de S. aureus contiguas al hongo.
Estas colonias eran macroscopicamente transparentes debido a un proceso de lisis (destrucción) bacteriana. Este hongo, que mas tarde fue identificado como Penicillium notatum, producía una sustancia ba -
Fleming descubre el fenómeno de la antibiosis
La antibiosis es una interacción biológica que consiste en la imposibilidad de vivir unos organismos en las inmediaciones de otros, debido a que éstos segregan una sustancia, llamada antibiótico, que provoca la muerte de aquellos -
Desarrollo de agentes antibacteriano,
Son productos metabolicos naturales de los hongos (actinomicetos) que provocan muerte bacteriana o inhiben el crecimiento de bacterias -
En 1935 el bioquímico estadounidense Wendell Stanley logró aislar y cristalizar un virus: el del mosaico del tabaco.
es un virus ARN que infecta plantas, especialmente al tabaco y a otros miembros de la familia Solanaceae. La infección produce manchas características en las hojas (de ahí su nombre) -
Una sulfamida (llamada en grupo sulfas)1 es una sustancia química sintética derivada de la sulfonamida, bacteriostática y de amplio espectro. Las sulfamidas se emplean como antibióticos, antiparasitarios y coccidiostáticos en el tratamiento de enfermedades infecciosas. Las sulfas son usadas tanto en medicina humana, como el sulfametoxazol, la sulfadiazina y la sulfabenzamida, así como veterinaria, como el sulfanitrato, el sulfapirazol y la sulfaquinoxalina. Las sulfonamida
-
existencia de terapias efectivas antimicrobianas frente a la mayoría de infecciones.
El uso de los agentes antimicrobianos en la terapéutica de las enfermedades infecciosas, ha constituido un acontecimiento sin precedentes, porque la curación y control de las infecciones permitió modificar favorablemente el panorama de la morbilidad y mortalidad en animales, en el que estas afecciones ocupan el primer lugar entre las causas de muerte. -
Aparición de la enfermedad del legionario (legionelosis).
La legionelosis es una enfermedad causada por las bacterias Legionella. Hay dos formas de la enfermedad, la más séria causa pulmonía. La mayoría de los casos ocurren como acontecimientos aislados pero han ocurrido brotes, por ejemplo el que sucedió en Philadelphia en 1976 entre un grupo de personas que atendían a una convención de la legión americana. Aquí es de donde viene el nombre "enfermedad de los Legionarios" -
existencia de terapias efectivas antimicrobianas frente a la mayoría de infecciones.
El uso de los agentes antimicrobianos en la terapéutica de las enfermedades infecciosas, ha constituido un acontecimiento sin precedentes, porque la curación y control de las infecciones permitió modificar favorablemente el panorama de la morbilidad y mortalidad en animales, en el que estas afecciones ocupan el primer lugar entre las causas de muerte. -
las investigaciones microbiológicas se sirvieron de diversas técnicas innovadoras, como el microscopio electrónico de barrido o las técnicas de secuenciación del ácido desoxirribonucleico (ADN). Gracias a todos estos avances, los microorganismos se clasificaron en función de su estructura molecular, incluyéndolos en tres reinos. De este modo, las bacterias forman el conjunto de los procariotas, es decir, organismos en los que el material genético, en forma de ADN, se encuentra libre en el citopl
-
Se hablo del ultimo caso de viruela en el mundo, ocurrido en forma natural, en Somalia. 3 años después fue declarada erradicada totalmente del mundo (1º enfermedad en conseguir este galardón.
-
El síndrome de inmunodeficiencia adquirida, conocido por su acrónimo sida,1 es el conjunto de enfermedades de muy diverso tipo (generalmente, procesos infecciosos o tumorales) que resultan de la infección por el virus de la inmunodeficiencia humana (VIH). El uso de medicamentos combinados puede controlar la replicación del virus y fortalecer el sistema inmunitario; la consecuencia es que la infección se convierte en crónica y no deriva en sida, algo que, en su evolución natural y en la mayoría d
-
Es de IBM y sale al mercado el 12 de agosto, casi dos décadas después de que el término PC (Computadores personales, por sus siglas en inglés) se utilizara en una serie de artículos futuristas en la revista New Scientist.
-
Luc Montaigner. Descubrimiento del VIH.
El virus de la inmunodeficiencia humana (VIH) es un lentivirus (de la familia Retroviridae), causante del síndrome de inmunodeficiencia adquirida (sida). Fue descubierto y considerado como el agente de la naciente epidemia de sida por el equipo de Luc Montagnier en Francia en 1983. El virión es esférico, dotado de una envoltura y con una cápside proteica. Su genoma es una cadena de ARN monocatenario que debe copiarse provisionalmente al ADN para poder mu -
Los estudiantes de Pekín, con apoyo de la población, hacen huelgas de hambre y manifestaciones pacíficas en favor de la democracia desde abril de 1989. Buscan cambios. En la Plaza de Tiananmen, entronizan una copia de la Estatua de la Libertad como "diosa de la democracia". El movimiento, originalmente tolerado, es aplastado con tanques el 4 de junio. Deja unos 800 muertos, miles de heridos y detenidos
-
Un viaje rutinario para poner en órbita un satélite de comunicaciones y demostrar la seguridad de los viajes espaciales termina en tragedia el 20 de enero. El transbordador espacial Challenger enluta al mundo al romperse y desintegrarse sobre el Atlántico a menos de dos minutos de su lanzamiento. Fallan los anillos que aseguran el ajuste de los cohetes y mueren los 7 miembros de la tripulación.
-
El fenómeno estalla económicamente con "rock en tu idioma", promovido por la disquera alemana BMG Ariola para impulsar y difundir el rock argentino, colombiano, español, mexicano y otros. Incluye nombres como Charly García, Miguel Ríos, Raúl Porchetto y a bandas como "Los enanitos verdes", "Soda estéreo", "Hombres G" y muchos otros.
-
Los estudiantes de Pekín, con apoyo de la población, hacen huelgas de hambre y manifestaciones pacíficas en favor de la democracia desde abril de 1989. Buscan cambios.
-
El 9 de noviembre de 1989, es derribado el Muro de Berlín que desde la década de los 60 dividía la ciudad, separando el lado perteneciente a la RFA y a la RDA, anticipando la pronta reunificación del país, la caída del régimen comunista de Alemania Oriental y el fin del comunismo.
-
Encefalopatía Espongiforme bovina “vacas locas” Creutzfeldt-Jakob.
La encefalopatía espongiforme bovina (EEB) o «enfermedad de las vacas locas» es una enfermedad de reciente aparición, perteneciente a una misteriosa familia de enfermedades emparentadas, muy raras en su mayoría. Los primeros casos de animales enfermos se declararon en el Reino Unido en 1986. En 1996 se detectó en el humano una nueva enfermedad, una variante de la Enfermedad de Creutzfeldt-Jakob, que se relacionó con la epidemia -
comienza el iniciando la última fase para la erradicación mundial de la infección natural por el virus de la polio
polio es una enfermedad infecciosa, también llamada polio (de manera abreviada), que afecta principalmente al sistema nervioso. La enfermedad la produce el virus poliovirus. Se llama infantil porque las personas que contraen la enfermedad son principalmente niños -
en 1938 se observaron por primera vez los virus gracias a la invención del microscopio electrónico.
Looking for a timeline maker?
Create timelines for projects, roadmaps, history, lessons, legal cases, and stories with Timetoast. Timetoast is a timeline maker for work, school, research, and stories.